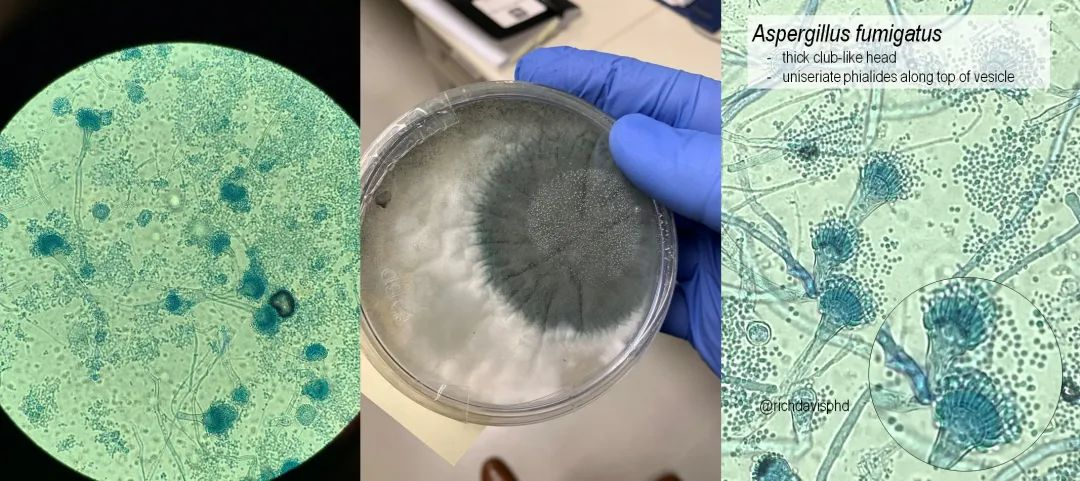

致命真菌蔓延!全美至少7个州出现,致死率最高达75%!(美中報道)
据每日邮报6月17日最新消息,一种可以从内部腐蚀人体组织的致命真菌正在美国迅速蔓延。
专家警告说,随着气温升高,问题可能会更加严重。
这种真菌被称为烟曲霉菌(Aspergillus fumigatus),通过空气传播,几乎无法避免。

由于它的孢子非常微小,人们吸入后几乎不会察觉,会导致一种称为曲霉病的严重肺部感染,对于脆弱人群,可导致器官衰竭和死亡。
约有40万例曲霉感染会发展为慢性肺曲霉病,这是一种长期肺部感染。而“侵袭性曲霉病(invasive aspergillosis)”虽然较少见,却更加致命。
对于免疫系统较弱的人,例如癌症患者、哮喘患者或艾滋病患者,尤其容易受到感染。

正常人即使吸入它的孢子,通常也不会发病,但当免疫系统遭到破坏时,它会在肺部迅速扩散、侵蚀组织,进而转移至大脑、心脏等多个器官。
•侵袭性曲霉病发病快、病死率高;
•一旦感染后果严重,器官移植或癌症患者死亡率超过40-75%;
•目前常用药物逐渐失效,抗药性菌株正在全球扩散。
科学家发现这种真菌已入侵美国部分地区,其中佛罗里达州、路易斯安那州、德克萨斯州、佐治亚州和加利福尼亚州由于气候炎热潮湿和农业活动的影响,受感染程度最高。
纽约、休斯顿和洛杉矶等大城市面临着人口密集和基础设施老化的额外风险。

重症监护室的尸检结果显示,曲霉病是四大致命感染之一。
一项研究发现,仅有59%的器官移植患者在感染后生存超过一年,干细胞移植患者的生存率更低,仅为25%。
世界卫生组织(WHO)已将烟曲霉列为“关键优先真菌威胁”,原因在于其抗药性上升和高死亡率。
研究发现,美国至少七个州的农田土壤中发现了对常用药物无效的烟曲霉,情况令人担忧。

对此,医生建议免疫系统较弱的人避免接触土壤、园艺和发霉的环境,在多尘的地方佩戴口罩,并保持医院和家中的空气清洁。
这种真菌在温暖潮湿的环境中极其活跃,甚至可以在堆肥堆中超过120华氏度(约49摄氏度)的高温中存活。广泛存在于泥土、落叶堆、堆肥、谷物储藏间、建筑工地,甚至是医院通风管道中。
而全球变暖,使得烟曲霉更容易适应人体内部环境。
曼彻斯特大学的一项新研究指出,到2100年该真菌的分布范围可能会扩大超过75%,使南部美国数百万人面临更高感染风险。
另外一方面,能够用于治疗人类真菌感染的阿唑类抗真菌药物(Azole drugs),被大量用于农业防霉。
专家警告,这种滥用正在导致真菌产生抗药性,而这些抗药性菌株可从环境传播到人体,使治疗变得无效。
哥伦比亚大学传染病专家维亚斯博士表示:“这不是科幻小说。这些感染是真实存在的,而我们还没准备好应对。”
世卫组织呼吁立即投资开发更安全的新药、更快的检测手段和医护人员培训,同时也呼吁制药企业将抗真菌研究列为优先事项,并将儿童纳入临床试验对象。
目前美国医院已加强霉菌检查和抗真菌措施。(一亩三分地)



